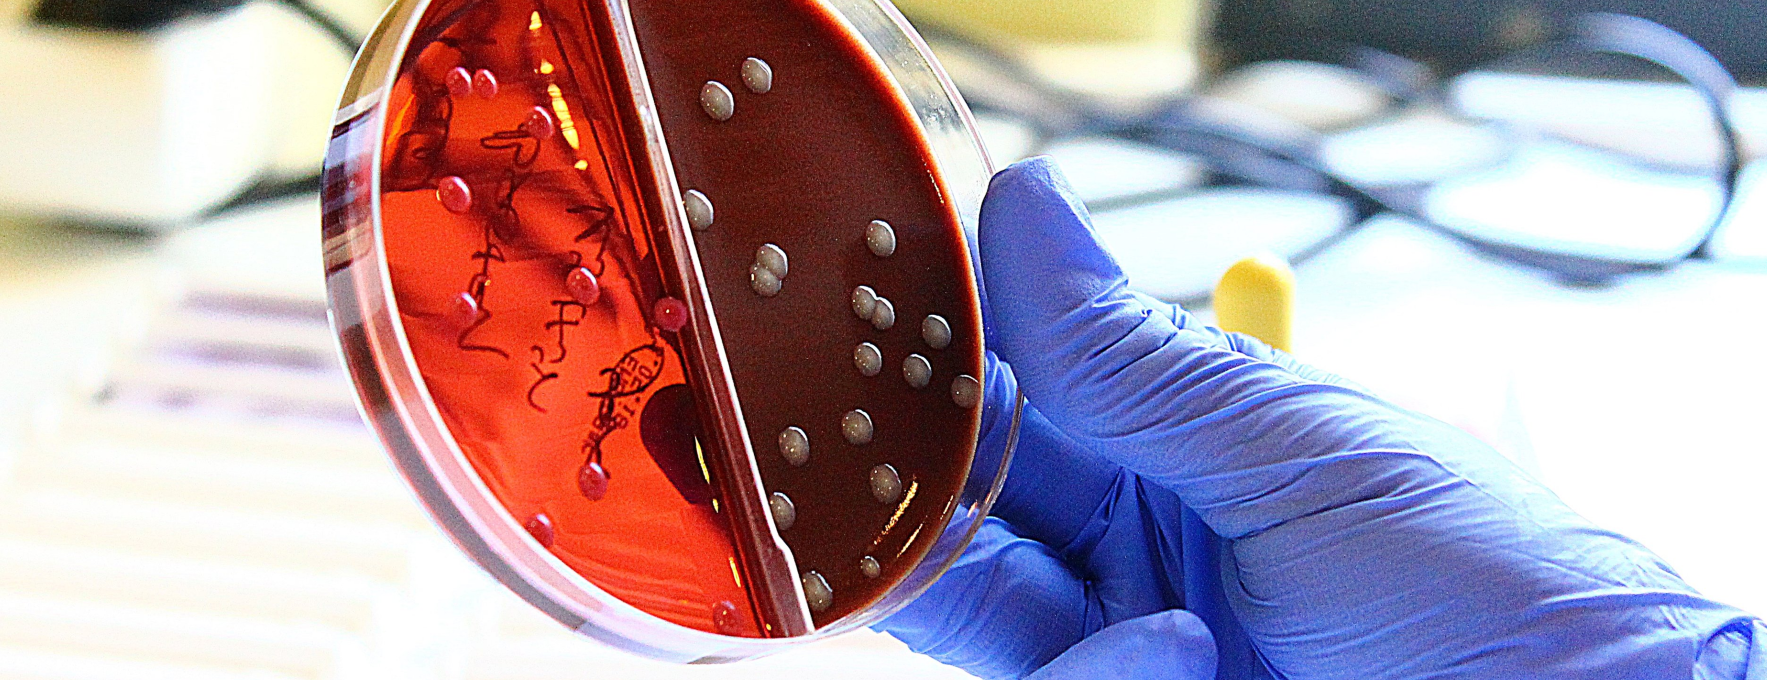

Sedimentation: It shows the difference in density between the liquid part of the blood with cells and other substances. If any cell or molecule (sugar, fats, proteins, defense systems, etc.) rises in the blood, the density of the blood increases, and the blood elements rapidly collapse according to the ratio of these elements. The higher this precipitation is at a specific time, it is understood that one or more substances above normal are found incorrectly in the blood. More detailed research is required to find this substance. It is the first sign of disease (infection, cancer, autoimmune diseases, febrile illnesses, etc.)
ASO (Antistreptolysin Antibody): Streptolysin is the name of the toxin secreted by bacteria called “Hemolytic streptococcus.” An examination to determine the presence of this toxin is called ASO. ASO is elevated in some Hemolytic Streptococcal infections such as rheumatism. Therefore, ASO values are important in diagnosis. An ASO above 300 indicates that the patient is carrying bacteria called streptococcus. A Group A streptococcal infection causes these values to increase, especially if there is an infection focus such as tonsillitis or dental abscess since these areas are not cleaned after an acute infection attack and continue to contain streptococci for anatomical reasons. ASO rises approximately 1-3 weeks after exposure to streptococcus. Sometimes it can stay as high as six months or even one year. It may increase in joint, kidney, or heart diseases. However, the high level of ASO does not indicate that these diseases exist for sure. It only shows that the streptococcal bacterium has entered the body.
CRP (C-Reactive Protein): C-reactive protein, commonly used abbreviation CRP, is one of the proteins called acute phase reactants, the amount of which increases in the blood during inflammatory reactions and is produced by the liver and fat cells. High CRP levels indicate an acute inflammatory reaction or infection in the body, and decreased levels of CRP indicate that the inflammatory reaction or infection has begun to fall.
RF (Rheumatoid Factor): It is a blood test that shows rheumatoid factor antibodies in the patient. Usually, antibodies are substances produced by the body’s immune system that defend against bacteria and viruses that cause disease. RF antibody, on the other hand, causes damage by attaching to normal body tissue and is found to be elevated in 80% of patients with rheumatoid arthritis.